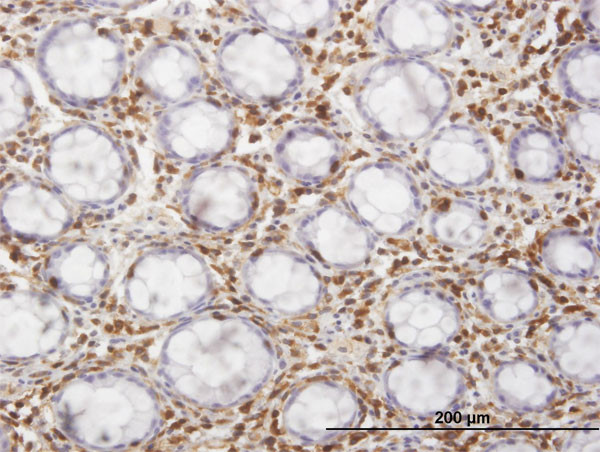
HCLS1 Antibody in Immunohistochemistry (Paraffin) (IHC (P))

Search
Abnova
HCLS1 Monoclonal Antibody (3F4)
{{$productOrderCtrl.translations['antibody.pdp.commerceCard.promotion.promotions']}}
{{$productOrderCtrl.translations['antibody.pdp.commerceCard.promotion.viewpromo']}}
{{$productOrderCtrl.translations['antibody.pdp.commerceCard.promotion.promocode']}}: {{promo.promoCode}} {{promo.promoTitle}} {{promo.promoDescription}}. {{$productOrderCtrl.translations['antibody.pdp.commerceCard.promotion.learnmore']}}
产品信息
H00003059-M04
宿主/亚型
分类
类型
克隆号
抗原
偶联物
形式
浓度
规格
保存条件
运输条件
产品详细信息
Sequence of this protein is as follows: QERKAVTKRS PEAPQPVIAM EEPAVPAPLP KKISSEAWPP VGTPPSSESE PVRTSREHPV PLLPIRQTLP EDNEEPPALP PRTLEGLQVE
靶标信息
Substrate of the antigen receptor-coupled tyrosine kinase. Plays a role in antigen receptor signaling for both clonal expansion and deletion in lymphoid cells. May also be involved in the regulation of gene expression. [UniProt]
仅用于科研。不用于诊断过程。未经明确授权不得转售。